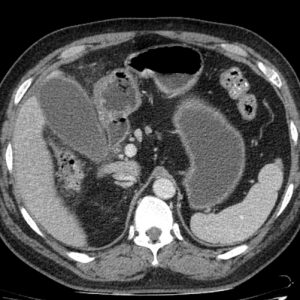
Viêm túi mật cấp
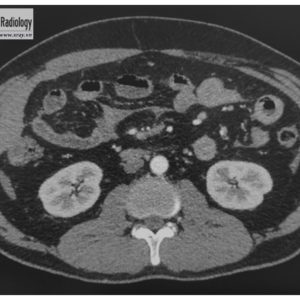
Chấn thương ruột

TIÊU HOÁ
Hiển thị 841–860 của 1445 kết quảĐã sắp xếp theo mới nhất
-

Thoát vị hoành
Lượt xem: 160» 02-09-2019 -

Nang gan
Lượt xem: 180» 02-09-2019 -

Thủng tạng rỗng
Lượt xem: 657» 23-08-2019 -

Viêm túi mật cấp
Lượt xem: 345» 23-08-2019 -

Thủng tạng rỗng
Lượt xem: 201» 20-08-2019 -

U giả nhầy phúc mạc
Lượt xem: 182» 17-08-2019 -

Tắc ruột
Lượt xem: 350» 14-08-2019 -

Viêm ruột thừa
Lượt xem: 159» 14-08-2019 -

U tụy
Lượt xem: 232» 30-07-2019 -

Ung thư tụy
Lượt xem: 267» 26-07-2019 -

Viêm ruột thừa
Lượt xem: 1135» 24-07-2019 -

U trực tràng
Lượt xem: 1187» 22-07-2019 -

HCC
Lượt xem: 1104» 22-07-2019 -

U mỡ gan
Lượt xem: 1113» 18-07-2019 -

Chấn thương ruột
Lượt xem: 1094» 17-07-2019 -

U cơ tuyến túi mật
Lượt xem: 1084» 17-07-2019 -

Chấn thương mạc treo
Lượt xem: 1059» 17-07-2019 -

HCC
Lượt xem: 92» 16-07-2019 -

HCC
Lượt xem: 149» 16-07-2019 -

HCC
Lượt xem: 181» 16-07-2019